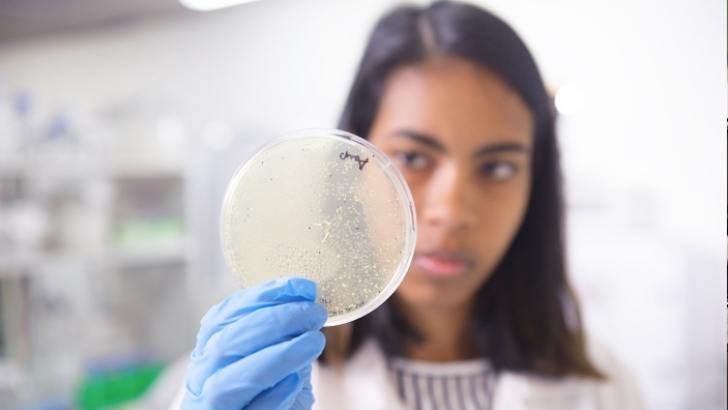

- Student-faculty ratios: 26.3
- Male to female ratio: 56 : 44
- School nature: Public
- Website: http://www.wits.ac.za/
- Address: 1 Jan Smuts Avenue, Braamfontein,Johannesburg, 2000,South Africa
- Phone: +27 011 717 1000
Commonly known as “Wits”, the University of the Witwatersrand developed out of the South African School of Mines, set up in Kimberley in 1896. The institution moved to Johannesburg in 1904 and acquired full university status in 1922. From the start, it embraced a philosophy of non-discrimination on the basis of race, which led to intense conflict with the government - including police raids and the detention of both faculty and students - during the apartheid era. Though located largely in the district of Braamfontein in central Johannesburg, a major expansion programme in the 1960s and 1970s saw the university establishing facilities in other areas of the city such as Hillbrow and Parktown. It also acquired two farms about 40 kilometres to the north-west, Sterkfontein and Swartkrans, which incorporate a celebrated set of limestone caves and have proved a rich source of archaeological remains. Its location in Johannesburg means that Wits is close to the economic powerhouse of the whole African continent. It was one of the founders of the African Research Universities Alliance and has an active programme of collaborative projects right across Africa and beyond. Highly research-intensive, it has made a major contribution to applied areas such as healthcare and the challenges of deep-level mining but performs strongly in subatomic physics and other fields of fundamental science. The most famous alumnus of the university is Nelson Mandela, who studied law there and went on to become President of South Africa and the 1993 Nobel laureate for peace. The novelist Nadine Gordimer (Nobel Prize for Literature, 1991) also attended for a year, while Aaron Klug (Nobel Prize for Chemistry, 1982) and Sydney Brenner (Nobel Prize for Medicine, 2002) both took their first degrees at Wits. Faculties
- Total number of students 28,279
- Number of international students 2,184
- Total number of academic staff 1,082
- Number of international staff 437
- Number of undergraduate degrees awarded 5,844
- Number of master's degrees awarded 1,442
- Number of doctoral degrees awarded 228
- Number of research only staff 362
- Number of new undergraduate students 8,274
- Number of new master's students 1,318
- Number of new doctoral students 221
- Global score 59.9
- Global research reputation #308
- Regional research reputation #3
- Publications #333
- Books #170
- Conferences #735
- Normalized citation impact #256
- Total citations #289
- Number of publications that are among the 10 percent most cited #342
- Percentage of total publications that are among the 10 percent most cited #539
- International collaboration #250
- Percentage of total publications with international collaboration #144
- Number of highly cited papers that are among the top 1 percent most cited #275
- Percentage of highly cited papers that are among the top 1 percent most cited #298
*The above data comes from: Official website of U.S.News
-

26.3
No. of students per staff
-

56 : 44
Student Ratio of Females to Males
-

8%
Percentage of International Students
-

28,521
Number of FTE Students
*The above data comes from: Official website of TIMES
-
World University Rankings
-
2012
251-275
-
2013
226-250
-
2014
226-250
-
2015
251-275
-
2016
201-250
-
2017
=182
-
2018
251–300
-
2019
201–250
-
2020
=194
-
-
Arts & humanities
-
2018
176–200
-
2019
151–175
-
-
Clinical, pre-clinical & health
-
2017
77
-
2018
101–125
-
2019
83
-
-
Engineering & technology
-
2018
401–500
-
2019
501–600
-
-
Life sciences
-
2019
251–300
-
-
Physical sciences
-
2019
501–600
-
-
Social sciences
-
2018
201–250
-
2019
126–150
-
-
Business & Economics
-
2019
301–400
-
-
Computer Science
-
2019
501–600
-
-
Law
-
2019
151+
-
-
Education
-
2019
251–300
-
-
Psychology
-
2019
301–400
-
-
Emerging Economies
-
2014
15
-
2015
14
-
2016
6
-
2017
8
-
2018
12
-
2019
11
-
*The above data comes from: Official website of TIMES
-
#155 Arts and Humanities
Show ranking metrics under this major
- Arts and Humanities overall score 42.7
- Arts and Humanities global research reputation #217
- Arts and Humanities regional research reputation #2
- Arts and Humanities publications #178
- Arts and Humanities books #217
- Arts and Humanities conferences #252
- Arts and Humanities normalized citation impact #54
- Arts and Humanities total citations #131
- Arts and Humanities number of publications that are among the 10 percent most cited #126
- Arts and Humanities percentage of total publications that are among the 10 percent most cited #36
- Arts and Humanities international collaboration #118
- Arts and Humanities percentage of total publications with international collaboration #124
-
#135 Clinical Medicine
Show ranking metrics under this major
- Clinical Medicine overall score 63.3
- Clinical Medicine global research reputation #291
- Clinical Medicine regional research reputation #5
- Clinical Medicine publications #383
- Clinical Medicine normalized citation impact #24
- Clinical Medicine total citations #199
- Clinical Medicine number of publications that are among the 10 percent most cited #299
- Clinical Medicine percentage of total publications that are among the 10 percent most cited #280
- Clinical Medicine international collaboration #226
- Clinical Medicine percentage of total publications with international collaboration #55
- Clinical Medicine number of highly cited papers that are among the top 1 percent most cited #188
- Clinical Medicine percentage of highly cited papers that are among the top 1 percent most cited #18
-
#448 Engineering
Show ranking metrics under this major
- Engineering overall score 41.9
- Engineering global research reputation #390
- Engineering regional research reputation #6
- Engineering publications #577
- Engineering normalized citation impact #435
- Engineering total citations #563
- Engineering number of publications that are among the 10 percent most cited #565
- Engineering percentage of total publications that are among the 10 percent most cited #467
- Engineering international collaboration #65
- Engineering percentage of total publications with international collaboration #81
- Engineering number of highly cited papers that are among the top 1 percent most cited #409
- Engineering percentage of highly cited papers that are among the top 1 percent most cited #250
-
#291 Environment/Ecology
Show ranking metrics under this major
- Environment/Ecology overall score 37.4
- Environment/Ecology global research reputation #261
- Environment/Ecology regional research reputation #5
- Environment/Ecology total citations #345
- Environment/Ecology number of publications that are among the 10 percent most cited #356
- Environment/Ecology percentage of total publications that are among the 10 percent most cited #348
- Environment/Ecology international collaboration #74
- Environment/Ecology percentage of total publications with international collaboration #138
- Environment/Ecology number of highly cited papers that are among the top 1 percent most cited #262
- Environment/Ecology percentage of highly cited papers that are among the top 1 percent most cited #243
-
#192 Geosciences
Show ranking metrics under this major
- Geosciences overall score 48.7
- Geosciences global research reputation #162
- Geosciences regional research reputation #2
- Geosciences total citations #193
- Geosciences number of publications that are among the 10 percent most cited #203
- Geosciences percentage of total publications that are among the 10 percent most cited #272
- Geosciences international collaboration #195
- Geosciences percentage of total publications with international collaboration #166
- Geosciences number of highly cited papers that are among the top 1 percent most cited #234
- Geosciences percentage of highly cited papers that are among the top 1 percent most cited #272
-
#104 Immunology
Show ranking metrics under this major
- Immunology overall score 42.5
- Immunology global research reputation #146
- Immunology regional research reputation #4
- Immunology publications #54
- Immunology normalized citation impact #156
- Immunology total citations #82
- Immunology number of publications that are among the 10 percent most cited #75
- Immunology percentage of total publications that are among the 10 percent most cited #140
- Immunology international collaboration #77
- Immunology percentage of total publications with international collaboration #7
- Immunology number of highly cited papers that are among the top 1 percent most cited #133
- Immunology percentage of highly cited papers that are among the top 1 percent most cited #177
-
#146 Microbiology
Show ranking metrics under this major
- Microbiology overall score 38.3
- Microbiology global research reputation #127
- Microbiology regional research reputation #2
- Microbiology publications #269
- Microbiology normalized citation impact #76
- Microbiology total citations #201
- Microbiology number of publications that are among the 10 percent most cited #183
- Microbiology percentage of total publications that are among the 10 percent most cited #104
- Microbiology international collaboration #200
- Microbiology percentage of total publications with international collaboration #61
- Microbiology number of highly cited papers that are among the top 1 percent most cited #130
- Microbiology percentage of highly cited papers that are among the top 1 percent most cited #56
-
#210 Physics
Show ranking metrics under this major
- Physics overall score 62.5
- Physics global research reputation #262
- Physics regional research reputation #4
- Physics publications #331
- Physics normalized citation impact #223
- Physics total citations #274
- Physics number of publications that are among the 10 percent most cited #256
- Physics percentage of total publications that are among the 10 percent most cited #169
- Physics international collaboration #320
- Physics percentage of total publications with international collaboration #98
- Physics number of highly cited papers that are among the top 1 percent most cited #269
- Physics percentage of highly cited papers that are among the top 1 percent most cited #227
-
#322 Plant and Animal Science
Show ranking metrics under this major
- Plant and Animal Science overall score 40.2
- Plant and Animal Science global research reputation #198
- Plant and Animal Science regional research reputation #4
- Plant and Animal Science publications #385
- Plant and Animal Science normalized citation impact #386
- Plant and Animal Science total citations #431
- Plant and Animal Science number of publications that are among the 10 percent most cited #372
- Plant and Animal Science percentage of total publications that are among the 10 percent most cited #338
- Plant and Animal Science international collaboration #327
- Plant and Animal Science percentage of total publications with international collaboration #218
- Plant and Animal Science number of highly cited papers that are among the top 1 percent most cited #411
- Plant and Animal Science percentage of highly cited papers that are among the top 1 percent most cited #413
-
#87 Social Sciences and Public Health
Show ranking metrics under this major
- Social Sciences and Public Health overall score 56.8
- Social Sciences and Public Health global research reputation #190
- Social Sciences and Public Health regional research reputation #2
- Social Sciences and Public Health publications #82
- Social Sciences and Public Health normalized citation impact #265
- Social Sciences and Public Health total citations #98
- Social Sciences and Public Health number of publications that are among the 10 percent most cited #108
- Social Sciences and Public Health percentage of total publications that are among the 10 percent most cited #348
- Social Sciences and Public Health international collaboration #29
- Social Sciences and Public Health percentage of total publications with international collaboration #40
- Social Sciences and Public Health number of highly cited papers that are among the top 1 percent most cited #74
- Social Sciences and Public Health percentage of highly cited papers that are among the top 1 percent most cited #144